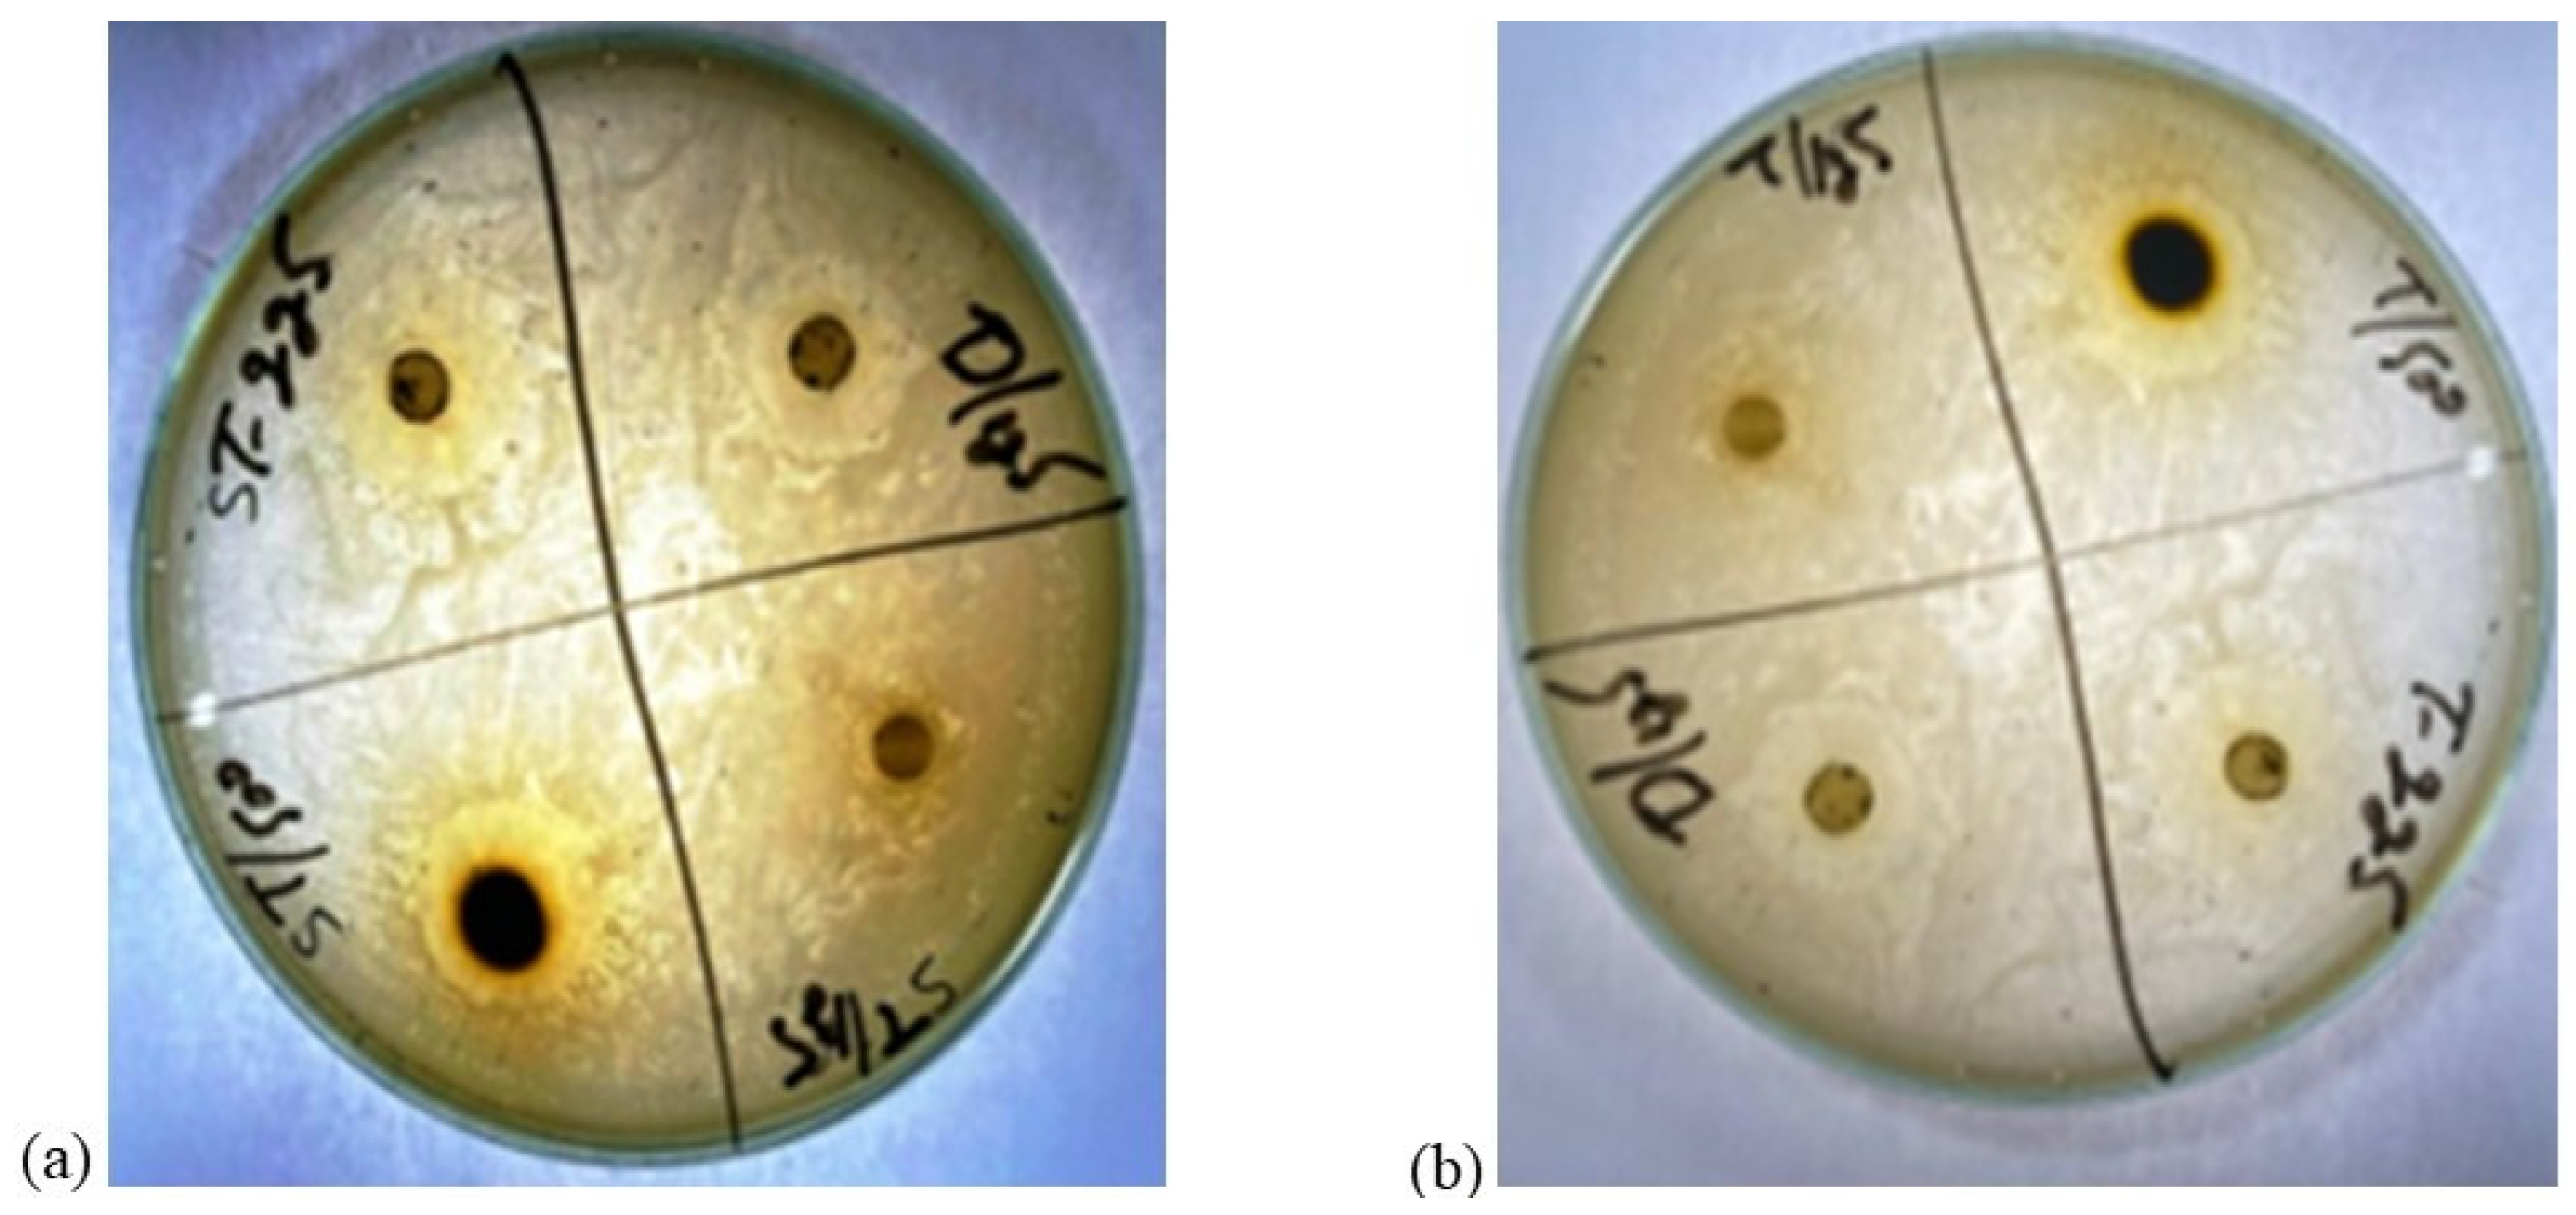
Microorganisms 11 02450 g001

Validating Interactions of Pathogenic Proteins of Staphylococcus aureus and E. coli with Phytochemicals of Ziziphus jujube and Acacia nilotica
Abstract
:1. Introduction
2. Materials and Methods
2.1. Isolation and Antibiotic Susceptibility Profile of Mastitis Milk Samples
2.2. Selection of Multiple Drug-Resistant Bacteria
2.3. Preparation of Plant Extracts and Determination of Antimicrobial Activity
2.4. Phytochemical Analysis of Extracts
2.5. Derivation of Bacterial Pathogenic Protein
2.6. Selection of Effective Phytocompounds:
2.7. Molecular Docking of Bacterial Proteins with Ligands of Extract
3. Results
3.1. Antimicrobial Resistance Profile of S. aureus and E. coli
3.2. Response of Multiple Drug-Resistant E. coli and S. aureus against Ethanolic Plants’ Extracts
3.3. Phytochemical Analysis of Plant Extract
3.4. Derivation of Bacterial Proteins
3.5. Molecular Docking of Bacterial Protein with Ligands of Phytocompounds
4. Discussion
5. Conclusions
Supplementary Materials
Author Contributions
Funding
Data Availability Statement
Acknowledgments
Conflicts of Interest
References
- AbdelKhalek, A.; Alanzi, J. Prevalence of Subclinical Mastitis in some Dairy Cattle Farms in Kuwait. Mansoura Veter. Med. J. 2019, 20, 46–51. [Google Scholar] [CrossRef]
- De Vries, A.; Marcondes, M.I. Review: Overview of factors affecting productive lifespan of dairy cows. Animal 2020, 14, s155–s164. [Google Scholar] [CrossRef] [PubMed]
- Dahl, G.E. Physiology of lactation in dairy cattle—Challenges to sustainable production. In Animal Agriculture; Academic Press: Cambridge, MA, USA, 2020; pp. 121–129. [Google Scholar]
- Khan, T.; Sankhe, K.; Suvarna, V.; Sherje, A.; Patel, K.; Dravyakar, B. DNA gyrase inhibitors: Progress and synthesis of potent compounds as antibacterial agents. Biomed. Pharmacother. 2018, 103, 923–938. [Google Scholar] [CrossRef] [PubMed]
- Bilal, M.Q.; Iqbal, M.U.; Muhammad, G.; Avais, M.; Sajid, M.S. Factors affecting the prevalence of clinical mastitis in buffaloes around Faisalabad district (Pakistan). Int. J. Agric. Biol. 2004, 6, 185–187. [Google Scholar]
- Mubarack, H.M.; Doss, A.; Vijayasanthi, M.; Venkataswamy, R. Antimicrobial drug susceptibility of Staphylococcus aureus from subclinical bovine mastitis in Coimbatore, Tamilnadu, South India. Vet. World 2012, 5, 352. [Google Scholar] [CrossRef]
- Lansky, E.P.; Paavilainen, H.M.; Lansky, S. Acacias: The Genus Acacia (Sensu Lato); CRC Press: Boca Raton, FL, USA, 2023; Volume 1. [Google Scholar]
- Salam, M.A.; Al-Amin, M.Y.; Salam, M.T.; Pawar, J.S.; Akhter, N.; Rabaan, A.A.; Alqumber, M.A. Antimicrobial Resistance: A Growing Serious Threat for Global Public Health. Healthcare 2023, 11, 1946. [Google Scholar] [CrossRef] [PubMed]
- Dattaray, D. Traditional Uses and Pharmacology of Plant Tridax procumbens: A Review. Syst. Rev. Pharm. 2022, 13, 476–482. [Google Scholar]
- Firyal, S.; Awan, A.R.; Sattar, H.; Ullah, H.K.R.; Tayyab, M.; Wasim, M.; Saeed, S.; Naseer, R.; Umer, M.O.; Rashid, I. Identification of polymorphism in bovine tumor necrosis factor alpha and toll-like receptor 4 genes and its association with mastitis in Sahiwal cows. Int. J. Agric. Biol. 2018, 20, 750–752. [Google Scholar]
- Kumari, S.; Naraian, R. Enhanced growth and yield of oyster mushroom by growth-promoting bacteria Glutamicibacter arilaitensis MRC119. J. Basic Microbiol. 2021, 61, 45–54. [Google Scholar] [CrossRef]
- Amber, R.; Adnan, M.; Tariq, A.; Khan, S.N.; Mussarat, S.; Hashem, A.; Al-Huqail, A.A.; Al-Arjani, A.F.; Abd Allah, E.F. Antibacterial activity of selected medicinal plants of northwest Pakistan traditionally used against mastitis in livestock. Saudi J. Biol. Sci. 2018, 25, 154–161. [Google Scholar] [CrossRef]
- Mitra, S.D.; Bandopadhyay, S.; Jadhao, S.; Shome, R.; Shome, B.R. Genetic characterization and comparative genomics of a multi drug resistant (MDR) Escherichia coli SCM-21 isolated from a subclinical case of bovine mastitis. Comp. Immunol. Microbiol. Infect. Dis. 2022, 85, 101799. [Google Scholar]
- Murtaza, M.; Aqib, A.I.; Khan, S.R.; Muneer, A.; Ali, M.M.; Waseem, A.; Zaheer, T.; Al-Keridis, L.A.; Alshammari, N.; Saeed, M. Sodium Alginate-Based MgO Nanoparticles Coupled Antibiotics as Safe and Effective Antimicrobial Candidates against Staphylococcus aureus of Houbara Bustard Birds. Biomedicines 2023, 11, 1959. [Google Scholar] [CrossRef] [PubMed]
- Muneer, A.; Kumar, S.; Aqib, A.I.; Khan, S.R.; Shah, S.Q.A.; Zaheer, I.; Rehman, T.U.; Abbas, A.; Hussain, K.; Rehman, A.; et al. Evaluation of Sodium Alginate Stabilized Nanoparticles and Antibiotics against Drug Resistant Escherichia coli Isolated from Gut of Houbara Bustard Bird. Oxidative Med. Cell. Longev. 2022, 2022, 7627759. [Google Scholar] [CrossRef]
- Roy, A.; Anand, A.; Garg, S.; Khan, M.S.; Bhasin, S.; Asghar, M.N.; Emran, T.B. Structure-based in silico investigation of agonists for proteins involved in breast cancer. Evid. Based Complement. Altern. Med. 2022, 2022, 7278731. [Google Scholar] [CrossRef] [PubMed]
- Liu, Y.; Yang, X.; Gan, J.; Chen, S.; Xiao, Z.X.; Cao, Y. CB-Dock2: Improved protein–ligand blind docking by integrating cavity detection, docking and homologous template fitting. Nucleic Acids Res. 2022, 50, W159–W164. [Google Scholar] [CrossRef] [PubMed]
- Anonymous. NIST Chemistry WebBook; NIST Standard Reference Database Number 69; Linstrom, P.J., Mallard, W.G., Eds.; National Institute of Standards and Technology: Gaithersburg, MD, USA, 2023. Available online: https://webbook.nist.gov/chemistry/ (accessed on 12 September 2023).
- Javed, M.R.; Salman, M.; Tariq, A.; Tawab, A.; Zahoor, M.K.; Naheed, S.; Shahid, M.; Ijaz, A.; Ali, H. The Antibacterial and Larvicidal Potential of Bis-(2-Ethylhexyl) Phthalate from Lactiplantibacillus plantarum. Molecules 2022, 27, 7220. [Google Scholar] [CrossRef]
- Cholewiński, G.; Iwaszkiewicz-Grześ, D.; Prejs, M.; Głowacka, A.; Dzierzbicka, K. Synthesis of the inosine 5′-monophosphate dehydrogenase (IMPDH) inhibitors. J. Enzym. Inhib. Med. Chem. 2015, 30, 550–563. [Google Scholar] [CrossRef] [PubMed]
- Reece, R.J.; Maxwell, A. DNA gyrase: Structure and function. Crit. Rev. Biochem. Mol. Biol. 1991, 26, 335–375. [Google Scholar] [CrossRef]
- Simon-Baram, H.; Roth, S.; Niedermayer, C.; Huber, P.; Speck, M.; Diener, J.; Richter, M.; Bershtein, S. A High-Throughput Continuous Spectroscopic Assay to Measure the Activity of Natural Product Methyltransferases. ChemBioChem 2022, 23, e202200162. [Google Scholar] [CrossRef] [PubMed]
- Pautsch, A.; Schulz, G.E. Structure of the outer membrane protein A transmembrane domain. Nat. Struct. Biol. 1998, 5, 1013–1017. [Google Scholar] [CrossRef]
- Kaushik, V.; Tiwari, M.; Tiwari, V. Interaction of RecA mediated SOS response with bacterial persistence, biofilm formation, and host response. Int. J. Biol. Macromol. 2022, 217, 931–943. [Google Scholar] [CrossRef] [PubMed]
- Varshney, A.K.; Wang, X.; Scharff, M.D.; MacIntyre, J.; Zollner, R.S.; Kovalenko, O.V.; Martinez, L.R.; Byrne, F.R.; Fries, B.C. Staphylococcal enterotoxin B–specific monoclonal antibody 20b1 successfully treats diverse Staphylococcus aureus Infections. J. Infect. Dis. 2013, 208, 2058–2066. [Google Scholar] [CrossRef] [PubMed]
- Audah, K.A.; Ettin, J.; Darmadi, J.; Azizah, N.N.; Anisa, A.S.; Hermawan, T.D.F.; Tjampakasari, C.R.; Heryanto, R.; Ismail, I.S.; Batubara, I. Indonesian Mangrove Sonneratia caseolaris Leaves Ethanol Extract Is a Potential Super Antioxidant and Anti Methicillin-Resistant Staphylococcus aureus Drug. Molecules 2022, 27, 8369. [Google Scholar] [CrossRef]
- Vanlalveni, C.; Lallianrawna, S.; Biswas, A.; Selvaraj, M.; Changmai, B.; Rokhum, S.L. Green synthesis of silver nanoparticles using plant extracts and their antimicrobial activities: A review of recent literature. RSC Adv. 2021, 11, 2804–2837. [Google Scholar] [CrossRef]
- Zemouri-Alioui, S.; Bachirbey, M.; Kurt, B.Z.; Sonmez, F.; Louaileche, H. Optimization of ultrasound-assisted extraction of total phenolic contents and antioxidant activity using response surface methodology from jujube leaves (Ziziphus jujuba) and evaluation of anticholinesterase inhibitory activity. J. Food Meas. Charact. 2019, 13, 321–329. [Google Scholar] [CrossRef]
- Song, L.; Liu, P.; Yan, Y.; Huang, Y.; Bai, B.; Hou, X.; Zhang, L. Supercritical CO2 fluid extraction of flavonoid compounds from Xinjiang jujube (Ziziphus jujuba Mill.) leaves and associated biological activities and flavonoid compositions. Ind. Crops Prod. 2019, 139, 111508. [Google Scholar] [CrossRef]
- Marques Casanova, J.; dos Santos Nascimento, L.B.; Marques Casanova, L.; Daflón Castricini, S.; Elis de Souza, J.; Kao Yien, R.M.; Sônia, S.C.; Schwartz Tavares, E. Kalanchoe fedtschenkoi R. Hamet & H. Perrier, a non-conventional food plant in Brazil: HPLC-DAD-ESI-MS/MS profile and leaf histochemical location of flavonoids. J. Appl. Bot. Food Qual. 2022, 95, 154. [Google Scholar]
- Charalambous, D.; Christoforou, M.; Kitiri, E.N.; Andreou, M.; Partassides, D.; Papachrysostomou, C.; Frantzi, M.; Karikas, G.A.; Pantelidou, M. Antimicrobial Activities of Saponaria cypria Boiss. Root Extracts, and the Identification of Nine Saponins and Six Phenolic Compounds. Molecules 2022, 27, 5812. [Google Scholar] [CrossRef]
- Kher, M.N.; Sheth, N.R.; Bhatt, V.D. In vitro antibacterial evaluation of Terminalia chebula as an alternative of antibiotics against bovine subclinical mastitis. Anim. Biotechnol. 2019, 30, 151–158. [Google Scholar] [CrossRef]
- Wink, M.; Botschen, G.C.; Schafer, H.; Waterman, P.G. Chemotaxonomy seen from a phylogenetic perspective and evolution of secondary metabolism. In Annual Plant Reviews; Biochemistry of Plant Secondary Metabolism; Chapter 7; Wink, M., Ed.; Blackwell: Oxford, UK, 2010; Volume 40. [Google Scholar]
- Bernard, F.X.; Sablé, S.; Cameron, B.; Provost, J.; Desnottes, J.F.; Crouzet, J.; Blanche, F. Glycosylated flavones as selective inhibitors of topoisomerase IV. Antimicrob. Agents Chemother. 1997, 41, 992–998. [Google Scholar] [CrossRef]
- Kolenc, Z.; Langerholc, T.; Hostnik, G.; Ocvirk, M.; Štumpf, S.; Pintarič, M.; Košir, I.J.; Čerenak, A.; Garmut, A.; Bren, U. Antimicrobial Properties of Different Hop (Humulus lupulus) Genotypes. Plants 2023, 12, 120. [Google Scholar] [CrossRef] [PubMed]
- Štumpf, S.; Hostnik, G.; Langerholc, T.; Pintarič, M.; Kolenc, Z.; Bren, U. The Influence of Chestnut Extract and Its Components on Antibacterial Activity against Staphylococcus aureus. Plants 2023, 12, 2043. [Google Scholar] [CrossRef] [PubMed]
- Lešnik, S.; Bren, U. Mechanistic Insights into Biological Activities of Polyphenolic Compounds from Rosemary Obtained by Inverse Molecular Docking. Foods 2022, 11, 67. [Google Scholar] [CrossRef] [PubMed]
- Kores, K.; Kolenc, Z.; Furlan, V.; Bren, U. Inverse Molecular Docking Elucidating the Anticarcinogenic Potential of the Hop Natural Product Xanthohumol and Its Metabolites. Foods 2022, 11, 1253. [Google Scholar] [CrossRef] [PubMed]
- Lešnik, S.; Jukič, M.; Bren, U. Mechanistic Insights of Polyphenolic Compounds from Rosemary Bound to Their Protein Targets Obtained by Molecular Dynamics Simulations and Free-Energy Calculations. Foods 2023, 12, 408. [Google Scholar] [CrossRef]

| Antibiotics Name | E. coli | S. aureus | ||||
|---|---|---|---|---|---|---|
| R (%) | I (%) | S (%) | R (%) | I (%) | S (%) | |
| Ampicillin | 50 | 20 | 30 | 40 | 30 | 30 |
| Enrofloxacin | 30 | 10 | 60 | 30 | 20 | 50 |
| Ciprofloxacin | 20 | 10 | 70 | 40 | 10 | 50 |
| Trimethoprim Sulfamethoxazole | 40 | 20 | 40 | 30 | 20 | 50 |
| Amikacin | 50 | 20 | 30 | 20 | 10 | 70 |
| Oxytetracycline | 20 | 30 | 50 | 30 | 20 | 50 |
| Vancomycin | 40 | 20 | 40 | 30 | 10 | 60 |
| Erythromycin | 10 | 20 | 70 | 40 | 20 | 40 |
| Linezolid | 20 | 30 | 50 | 20 | 20 | 60 |
| Azithromycin | 30 | 30 | 40 | 30 | 20 | 50 |
| Effect of Ziziphus jujube | |||
|---|---|---|---|
| Bacteria | Extract Concentration (mg/mL) | Inhibition Zone Diameter (mm) | Erythromycin * (125 mg/mL) |
| S. aureus | 500 mg/mL 225 mg/mL 125 mg/mL | 21 mm 19 mm 18 mm | 17 mg/mL |
| E. coli | 500 mg/mL 225 mg/mL 125 mg/mL | 23 mm 21 mm 18 mm | 15 mg/mL |
| Efficacy of Acacia nilotica | |||
| Isolates | Extract Concentration (mg/mL) | Inhibition Zone Diameter (mm) | Amoxicillin (125 mg/mL) |
| S. aureus | 500 mg/mL 125 mg/mL | 20 mm 18 mm | 17 mg/mL |
| E. coli | 500 mg/mL 125 mg/mL | 23 mm 21 mm | 15 mg/mL |
| Sr. No. | Peak Compounds | 2D Structure | Molecular Weight (g/mol) | Retention Time (min) | Area Sum (%) | Formula | Classification |
|---|---|---|---|---|---|---|---|
| 1 | 2-Cyclopenten-1-one,3,4,4-trimethyl- | ![]() | 124.18 g/mol | 9.524 m | 4.93% | C8H12O | Reported to exhibit the higher tumor-specific cytotoxicity against oral human normal and tumor cells |
| 2 | Benzenepropanal, 4-(1,1-dimethylethyl)- | ![]() | 190.28 g/mol | 14.107 m | 4.40% | C13H18O | Not reported |
| 3 | Oxalic acid, dodecyl isobutyl ester | ![]() | 300.43 g/mol | 18.954 m | 0.85% | C17H32O4 | Not reported |
| 4 | 2,4-Di-tert-butylphenol | ![]() | 192.30 g/mol | 20.808 m | 4.12% | C13H20O | It has a role as a bacterial metabolite, an antioxidant, and a marine metabolite. It is an alkylbenzene and a member of phenols |
| 5 | Azelaic acid | ![]() | 172.22 g/mol | 22.490 m | 2.05% | C9H16O3 | It has a role as an antibacterial agent, an antineoplastic agent, a dermatologic drug, and a plant metabolite |
| 6 | Pentadecanoic acid, 14-methyl-, methyl ester | ![]() | 256.42 g/mol | 29.946 m | 2.00% | C16H32O2 | Not reported |
| 7 | n-Hexadecanoic acid | ![]() | 240.42 g/mol | 30.621 m | 15.16% | C16H32O | It has a role as an EC 1.1.1.189 (prostaglandin-E2 9 reductase) inhibitor, a plant metabolite, a Daphnia magna metabolite, and an algal metabolite |
| 8 | Octadecanoic acid, 9,10-dihydroxy, methyl ester | ![]() | 456.77 g/mol | 31.285 m | 2.88% | C26H52O4Si | Not reported |
| 9 | Phytol | ![]() | 282.50 g/mol | 33.591 m | 17.73% | C19H38O | It has a role as a plant metabolite, a schistosomicide drug, and an algal metabolite. It is a diterpenoid and a long-chain primary fatty alcohol |
| 10 | 9,12,15-Octadecatrien-1-ol, (Z,Z,Z)- | ![]() | 248.45 g/mol | 34.054 m | 9.80% | C18H32 | It has a role as an antibacterial agent |
| 11 | Octadecanoic acid | ![]() | 268.48 g/mol | 34.409 m | 4.91% | C18H36O | It has a role as a plant metabolite, a human metabolite, a Daphnia magna metabolite, and an algal metabolite |
| 12 | Bis(2-ethylhexyl) phthalate | ![]() | 376.53 g/mol | 34.621 m | 5.94% | C23H36O4 | Di(2-ethylhexyl) phthlate (DEHP) is a manufactured chemical that is commonly added to plastics to make them flexible |
| 13 | Methyl 9-cis,11-trans-octadecadienoate | ![]() | 280.45 g/mol | 34.947 m | 8.98% | C18H32O2 | Not reported |
| Sr. No. | Peak Compounds | 2D Structure | Formula | Molecular Weight (g/mol) | Retention Time (min) | Area Sum (%) | Classification |
|---|---|---|---|---|---|---|---|
| 1 | Nonanoic acid | ![]() | C9H18O2 | 158.24 g/mol | 12.528 m | 4.72% | Antibacterial (reduce bacterial translocation) |
| 2 | Methyl 8-oxooctanoate | ![]() | C9H16O3 | 172.22 g/mol | 14.645 m | 0.94% | Anticancer |
| 3 | Nonanoic acid, 9-oxo-, methyl ester | ![]() | C10H18O3 | 186.25 g/mol | 18.159 m | 1.91% | Antimicrobial, antioxidant (cancer) |
| 4 | Suberic acid monomethyl ester | ![]() | C9H16O4 | 188.22 g/mol | 19.875 m | 2.71% | Antibacterial (growth inhibition) |
| 5 | Nonanedioic acid, dimethyl ester | ![]() | C11H20O4 | 216.27 g/mol | 22.530 m | 12.83% | Bacteriostatic, antioxidant (inhibitor of mitochondrial oxidoreductases) |
| 6 | 2,2,4-Trimethyl-1,3-pentanediol diisobutyrate | ![]() | C16H30O4 | 286.41 g/mol | 22.730 m | 1.06% | Antibacterial |
| 7 | 1,2-Benzenedicarboxylic acid, bis(2-methylpropyl) ester | ![]() | C16H22O4 | 278.34 g/mol | 28.881 m | 1.38% | Antibacterial, Antimicrobial |
| 8 | Hexadecanoic acid, methyl ester | ![]() | C17H34O2 | 270.5 g/mol | 29.951 m | 29.35% | Antiandrogenic (autolysis of membrane structure, especially mitochondria) |
| 9 | n-Hexadecanoic acid | ![]() | C16H32O2 | 256.42 g/mol | 30.638 m | 3.88% | Antibacterial (hydrolysis of membrane phospholipid) |
| 10 | Cyclic octaatomic sulfur | ![]() | S8 | 256.5 g/mol | 32.629 m | 1.73% | Bacterial metabolite |
| 11 | 11-Octadecenoic acid, methyl ester | ![]() | C19H36O2 | 296.5 g/mol | 33.362 m | 13.10% | Antioxidant |
| 12 | 9-Octadecenoic acid (z)-, methyl ester | ![]() | C19H36O2 | 296.5 g/mol | 33.459 m | 1.74% | Antimicrobial |
| 13 | Methyl stearate | ![]() | C19H38O2 | 298.5 g/mol | 33.802 m | 5.43% | Anticancer (unfolding of protein) |
| 14 | 9-Octadecenoic acid, (E)- | ![]() | C18H34O2 | 282.5 g/mol | 34.026 m | 1.97% | Antiviral, antioxidant |
| 15 | Methyl-9-cis,11-trans-octadecadienoate | ![]() | C19H34O2 | 294.5 g/mol | 34.117 m | 1.83% | Anticarcinogenic |
| 16 | Octadecanoic acid | ![]() | C18H36O2 | 284.5 g/mol | 34.420 m | 1.44% | Antibacterial |
| 17 | Octadecanoic acid, 10-oxo-, methyl ester | ![]() | C19H36O3 | 312.5 g/mol | 37.287 m | 3.84% | Antibacterial, Antitumor |
| 18 | 1H-Pyrrol-1-yloxy, 3(aminocarbonyl)-2,5-dihydro-2,2,5,5-tetramethyl | Has no 2D structure | C9H15N2O2 | 183.2276 g/mol | 38.500 m | 7.63% |
| Sr. No. | Phytocompounds | Molecular Formula | Mode of Action | Lipinski Rule | ADMET Rule |
|---|---|---|---|---|---|
| 1 | 2-Cyclopenten-1-one,3,4,4-trimethyl- | C8H12O | Antibacterial | Yes | Molecular weight = 124.18 g/mol GI absorption = High Water solubility = soluble Leadlikeness = No TPSA = 17.07 Å2 CYP1A2 inhibitor = No CYP2C19 inhibitor = No CYP2C9 inhibitor = No CYP2D6 inhibitor = No CYP3A4 inhibitor = No Consensus Log Po/w = 1.80 |
| 2 | Benzenepropanal, 4-(1,1-dimethylethyl)- | C13H18O | Skin allergic | Yes | Molecular weight = 190.28 g/mol GI absorption = High Water solubility = Moderately soluble Leadlikeness = No TPSA = 17.07 Ų CYP1A2 inhibitor = No CYP2C19 inhibitor = No CYP2C9 inhibitor = No CYP2D6 inhibitor = Yes CYP3A4 inhibitor = No Consensus Log Po/w = 3.21 |
| 3 | Oxalic acid, dodecyl isobutyl ester | C17H32O4 | Yes | Molecular weight = 300.43 g/mol GI absorption = High Water solubility = Moderately soluble Leadlikeness = No TPSA = 52.60 Ų CYP1A2 inhibitor = Yes CYP2C19 inhibitor = No CYP2C9 inhibitor = No CYP2D6 inhibitor = No CYP3A4 inhibitor = No Consensus Log Po/w = 4.83 | |
| 4 | 2,4-Di-tert-butylphenol | C13H20O | Antibacterial; Anti-inflammatory; Antiviral | Yes | Molecular weight = 192.30 g/mol GI absorption = High Water solubility = Soluble Leadlikeness = No TPSA =20.23 Å2 CYP1A2 inhibitor = No CYP2C19 inhibitor = No CYP2C9 inhibitor = No CYP2D6 inhibitor = Yes CYP3A4 inhibitor = No Consensus Log Po/w = 3.69 |
| 5 | Azelaic acid | C9H16O3 | Anti-inflammatory | Yes | Molecular weight = 172.22 g/mol GI absorption = High Water solubility = Soluble Leadlikeness = No TPSA = 54.37 Å2 CYP1A2 inhibitor = No CYP2C19 inhibitor = No CYP2C9 inhibitor = No CYP2D6 inhibitor = No CYP3A4 inhibitor = No Consensus Log Po/w = 1.71 |
| 6 | Pentadecanoic acid, 14-methyl-, methyl ester | C16H32O2 | Antibacterial; Antifungal | Yes | Molecular weight = 256.42 g/mol GI absorption = High Water solubility = Moderately soluble Leadlikeness = No TPSA = 37.30 Å2 CYP1A2 inhibitor = Yes CYP2C19 inhibitor = No CYP2C9 inhibitor = No CYP2D6 inhibitor = No CYP3A4 inhibitor = No Consensus Log Po/w = 5.07 |
| 7 | n-Hexadecanoic acid | C16H32O | Antibacterial | Yes | Molecular weight = 240.42 g/mol GI absorption = High Water solubility = Moderately soluble Leadlikeness = No TPSA = 17.07 Ų CYP1A2 inhibitor = Yes CYP2C19 inhibitor = No CYP2C9 inhibitor = No CYP2D6 inhibitor = No CYP3A4 inhibitor = No Consensus Log Po/w = 5.43 |
| 8 | Octadecanoic acid, 9,10-dihydroxy, methyl ester | C26H52O4Si | Anti-inflammatory | Yes | Molecular weight = 456.77 g/mol GI absorption = Low Water solubility = Poorly soluble Leadlikeness = No TPSA = 55.76 Å2 CYP1A2 inhibitor = Yes CYP2C19 inhibitor = No CYP2C9 inhibitor = No CYP2D6 inhibitor = No CYP3A4 inhibitor = No Consensus Log Po/w = 6.92 |
| 9 | Phytol | C19H38O | Antibacterial | Yes | Molecular weight = 282.50 g/mol GI absorption = High Water solubility = Moderately soluble Leadlikeness = No TPSA = 20.23 Å2 CYP1A2 inhibitor = No CYP2C19 inhibitor = No CYP2C9 inhibitor = Yes CYP2D6 inhibitor = No CYP3A4 inhibitor = No Consensus Log Po/w = 5.91 |
| 10 | 9,12,15-Octadecatrien-1-ol, (Z,Z,Z)- | C18H32 | Antioxidant | Yes | Molecular weight = 248.45 g/mol GI absorption = Low Water solubility = Moderately soluble Leadlikeness = No TPSA = 0.00 Å2 CYP1A2 inhibitor = Yes CYP2C19 inhibitor = No CYP2C9 inhibitor = Yes CYP2D6 inhibitor = No CYP3A4 inhibitor = No Consensus Log Po/w = 6.30 |
| 11 | Octadecanoic acid | C18H36O | Antibacterial; Antifungal | Yes | Molecular weight = 268.48 g/mol GI absorption = Low Water solubility = Poorly soluble Leadlikeness = No TPSA = 17.07 Å2 CYP1A2 inhibitor = Yes CYP2C19 inhibitor = No CYP2C9 inhibitor = No CYP2D6 inhibitor = No CYP3A4 inhibitor = No Consensus Log Po/w = 6.17 |
| 12 | Bis(2-ethylhexyl) phthalate | C23H36O4 | Antimicrobial; Cytotoxic | Yes | Molecular weight = 376.53 g/mol GI absorption = High Water solubility = Poorly soluble Leadlikeness = No TPSA = 52.60 Å2 CYP1A2 inhibitor = No CYP2C19 inhibitor = No CYP2C9 inhibitor = Yes CYP2D6 inhibitor = No CYP3A4 inhibitor = Yes Consensus Log Po/w = 5.76 |
| 13 | Methyl 9-cis,11-trans-octadecadienoate | C18H32O2 | Anticarcinogenic; Anti-atherogenic | Yes | Molecular weight = 280.45 g/mol GI absorption = High Water solubility= Moderately soluble Leadlikeness = No TPSA =37.30 Ų CYP1A2 inhibitor = Yes CYP2C19 inhibitor = No CYP2C9 inhibitor = Yes CYP2D6 inhibitor = No CYP3A4 inhibitor = No Consensus Log Po/w = 5.47 |
| Sr. No. | Phytocompounds | Lipinski Rule | ADMET Rule |
|---|---|---|---|
| 1 | Nonanoic acid | Yes | Molecular weight = 158.24 Consensus Log Po/w =2.78 TP SA =17.07 Ų GI absorption = high Water solubility = soluble No; 1 violation: MW < 250 CYP1A2 inhibitor = No CYP2C19 inhibitor = No CYP2C9 inhibitor = No CYP2D6 inhibitor = No CYP3A4 inhibitor = No |
| 2 | Methyl 8-oxooctanoate | Yes | Consensus Log Po/w = 2.70 TPSA = 26.30 Ų GI absorption = high Water solubility = soluble No; 2 violations: MW < 250, XLOGP3 > 3.5 CYP1A2 inhibitor = No CYP2C19 inhibitor = No CYP2C9 inhibitor = No CYP2D6 inhibitor = No CYP3A4 inhibitor = No |
| 3 | Nonanoic acid, 9-oxo-, methyl ester | Yes | Molecular weight = 172.26 Consensus Log Po/w =3.13 TPSA =26.30 Ų GI absorption = high Water solubility = soluble No; 3 violations: MW < 250, Rotors > 7, XLOGP3 > 3.5 CYP1A2 inhibitor = No CYP2C19 inhibitor = No CYP2C9 inhibitor = No CYP2D6 inhibitor = No CYP3A4 inhibitor = No |
| 4 | Suberic acid monomethyl ester | Yes | Molecular weight = 172.22 Consensus Log Po/w = 1.82 TPSA = 43.37 Ų GI absorption = high Water solubility = soluble No; 2 violations: MW < 250, Rotors > 7 CYP1A2 inhibitor = No CYP2C19 inhibitor = No CYP2C9 inhibitor = No CYP2D6 inhibitor = No CYP3A4 inhibitor =No |
| 5 | Nonanedioic acid, dimethyl ester | Yes | Molecular weight = 202.25 Consensus Log Po/w =1.93 TPSA = 63.60Ų GI absorption = high Water solubility = soluble No; 2 violations: MW < 250, Rotors > 7 CYP1A2 inhibitor = No CYP2C19 inhibitor = No CYP2C9 inhibitor = No CYP2D6 inhibitor = No CYP3A4 inhibitor = No |
| 6 | 2,2,4-Trimethyl-1,3-pentanediol diisobutyrate | Yes | Molecular weight = 272.38 Consensus Log Po/w = 3.42 TPSA = 52.60 Ų GI absorption = high Water solubility = soluble No; 2 violations: Rotors > 7, XLOGP3 > 3.5 CYP1A2 inhibitor = No CYP2C19 inhibitor = Yes CYP2C9 inhibitor = No CYP2D6 inhibitor = No CYP3A4 inhibitor = No |
| 7 | 1,2-Benzenedicarboxylic acid, bis(2-methylpropyl) ester | Yes | Molecular weight = 264.32 Consensus Log Po/w = 3.30 No; 2 violations: Rotors > 7, XLOGP3 > 3.5 TPSA = 52.60 Ų GI absorption = high Water solubility= moderately soluble CYP1A2 inhibitor = Yes CYP2C19 inhibitor = Yes CYP2C9 inhibitor = No CYP2D6 inhibitor = No CYP3A4 inhibitor = No |
| 8 | Hexadecanoic acid, methyl ester | Yes | Molecular weight = 256.42 Consensus Log Po/w = 5.20 TPSA = 37.30 Ų GI absorption = high Water solubility = moderately soluble No; 2 violations: Rotors > 7, XLOGP3 > 3.5 CYP1A2 inhibitor = Yes CYP2C19 inhibitor = No CYP2C9 inhibitor = Yes CYP2D6 inhibitor = No |
| 9 | n-Hexadecanoic acid | Yes | Molecular weight = 240.42 Consensus Log Po/w = 5.43 TPSA = 17.07 Ų GI absorption = high Water solubility = moderately soluble No; 3 violations: MW < 250, Rotors > 7, XLOGP3 > 3.5 CYP1A2 inhibitor = Yes CYP2C19 inhibitor = No CYP2C9 inhibitor = No CYP2D6 inhibitor = No |
| 10 | Cyclic octa-atomic sulfur | Molecular weight = 256.52 Consensus Log Po/w = TPSA =202.40 Ų GI absorption = Water solubility = soluble No; violation CYP1A2 inhibitor = CYP2C19 inhibitor = CYP2C9 inhibitor = CYP2D6 inhibitor = CYP3A4 inhibitor = | |
| 11 | 11-Octadecenoic acid, methyl ester | Yes | Molecular weight = 282.46 Consensus Log Po/w =5.65 TPSA =37.30 Ų GI absorption = high Water solubility = moderately soluble No; 2 violations: Rotors > 7, XLOGP3 > 3.5 CYP1A2 inhibitor = Yes CYP2C19 inhibitor = No CYP2C9 inhibitor = Yes CYP2D6 inhibitor = No CYP3A4 inhibitor = No |
| 12 | 9-Octadecenoic acid (z)-, methyl ester | Yes | Molecular weight = 284.48 Consensus Log Po/w =5.93 TPSA = 37.30 Ų GI absorption = high Water solubility = poorly soluble No; 2 violations: Rotors > 7, XLOGP3 > 3.5 CYP1A2 inhibitor = Yes CYP2C19 inhibitor = No CYP2C9 inhibitor = No CYP2D6 inhibitor = No CYP3A4 inhibitor = No |
| 13 | Methyl stearate | Yes | Molecular weight = 284.48 Consensus Log Po/w =5.93 TPSA =37.30 Ų GI absorption = high Water solubility = poorly soluble No; 2 violations: Rotors > 7, XLOGP3 > 3.5 CYP1A2 inhibitor = Yes CYP2C19 inhibitor = No CYP2C9 inhibitor = No CYP2D6 inhibitor = No |
| 14 | 9-Octadecenoic acid, (E)- | Yes | Molecular weight = 266.46 Consensus Log Po/w = 5.94 TPSA = 17.07 Ų GI absorption = low Water solubility = moderately soluble No; 2 violations: Rotors > 7, XLOGP3 > 3.5 CYP1A2 inhibitor = Yes CYP2C19 inhibitor = No CYP2C9 inhibitor = No CYP2D6 inhibitor = No CYP3A4 inhibitor = No |
| 15 | Methyl-9-cis,11-trans-octadecadienoate | Yes | Molecular weight = 393.52 Consensus Log Po/w =3.72 TPSA = 86.23 Ų GI absorption = high Water solubility = soluble No; 3 violations: MW > 350, Rotors > 7, XLOGP3 > 3.5 CYP1A2 inhibitor = Yes CYP2C19 inhibitor = Yes CYP2C9 inhibitor = Yes CYP2D6 inhibitor = No CYP3A4 inhibitor = Yes |
| 16 | Octadecanoic acid | Yes | Molecular weight = 268.48 Consensus Log Po/w = 6.17 TPSA = 17.07 Ų GI absorption = low Water solubility = poorly soluble No; 2 violations: Rotors > 7, XLOGP3 > 3.5 CYP1A2 inhibitor = Yes CYP2C19 inhibitor = No CYP2C9 inhibitor = No CYP2D6 inhibitor = No CYP3A4 inhibitor = No |
| 17 | Octadecanoic acid, 10-oxo-, methyl ester | Yes | Molecular weight = 298.46 TPSA =54.37 Ų GI absorption = high Water solubility = moderately soluble No; 2 violations: Rotors > 7, XLOGP3 > 3.5 CYP1A2 inhibitor = Yes CYP2C19 inhibitor = No CYP2C9 inhibitor = No CYP2D6 inhibitor = No CYP3A4 inhibitor =No |
| 18 | 1H-pyrrol-1-yloxy,-3(aminocarbonyl)-2,5-dihydro-2,2,5,5-tetramethyl | Molecular weight= Consensus Log Po/w = TPSA = Ų GI absorption = Water solubility = No; 1 violation: MW< CYP1A2 inhibitor = No CYP2C19 inhibitor = No CYP2C9 inhibitor = No CYP2D6 inhibitor = No CYP3A4 inhibitor = No |
| Sr. No. | Phytocompounds | Molecular Formula | Activity | ADMET Rule |
|---|---|---|---|---|
| 1 | 2-Cyclopenten-1-one,3,4,4-trimethyl- | C8H12O | Antibacterial [18] | Molecular weight = 124.18 g/mol GI absorption = High Water solubility = Soluble Leadlikeness = No TPSA =17.07 Ų CYP1A2 inhibitor = No CYP2C19 inhibitor = No CYP2C9 inhibitor = No CYP2D6 inhibitor = No CYP3A4 inhibitor = No Consensus Log Po/w = 1.80 |
| 2 | Bis(2-ethylhexyl) phthalate | C23H36O4 | Antimicrobial; Cytotoxic [19] | Molecular weight = 376.53 g/mol GI absorption = High Water solubility= Poorly soluble Leadlikeness =No TPSA =52.60 Ų CYP1A2 inhibitor = No CYP2C19 inhibitor = No CYP2C9 inhibitor = Yes CYP2D6 inhibitor = No CYP3A4 inhibitor = Yes Consensus Log Po/w = 5.76 |
| Sr. No. | Phytocompounds | Activity | Lipinski Rule | ADMET Rule |
|---|---|---|---|---|
| 1 | Suberic acid monomethyl ester | Antibacterial [20] | Yes | Molecular weight = 172.22 Consensus Log Po/w = 1.82 TPSA = 43.37 Ų GI absorption = high Water Solubility= soluble No; 2 violations: MW < 250, Rotors > 7 CYP1A2 inhibitor = No CYP2C19 inhibitor = No CYP2C9 inhibitor = No CYP2D6 inhibitor = No CYP3A4 inhibitor = No |
| 2 | 2,2,4-trimethyl-1,3-pentanediol di-iso-butyrate | Antibacterial [2] | Yes | Molecular weight = 272.38 Consensus Log Po/w = 3.42 TPSA = 52.60 Ų GI absorption = high Water Solubility = soluble No; 2 violations: Rotors > 7, XLOGP3 > 3.5 CYP1A2 inhibitor = No No CYP2C19 inhibitor = Yes No CYP2C9 inhibitor = No No CYP2D6 inhibitor = No No CYP3A4 inhibitor = No No |
| Sr. No. | Proteins | Mode of Action | Reference |
|---|---|---|---|
| 1 | 5L3J DNA Gyrase E. coli protein | DNA Gyrase is proven to be validated targets in the design of novel antibacterial drugs | [21] |
| 2 | TSST-1 2QIL S. aureus protein | TSST-1 is a super antigen that stimulates release of cytokines, producing leakage of endothelial cells at low concentrations and a cytotoxic effect to the cells at high concentrations | [22] |
| Sr. No. | Proteins | Mode of action | Reference |
|---|---|---|---|
| 1 | 1BXW Outer membrane protein A E. coli protein | Outer membrane protein enables intracellular survival, evasion from the body’s defense. | [23] |
| 2 | 3FV5 Topoisomerase IV E. coli protein | Topoisomerase IV helps in creating pores in membranes of host cells (cell lysis) and catalyzing a DNA double-strand break. | [24] |
| 3 | 2QIL Toxic shock syndrome toxin-1 S. aureus protein | TSST-1 is a super antigen that stimulates release of cytokines, producing leakage of endothelial cells at low concentrations and a cytotoxic effect to the cells at high concentrations. | [22] |
| 4 | 3SEB Enterotoxin B S. aureus protein | Enterotoxin B helps in the stimulation of cytokine release and inflammation. | [25] |
| Ziziphus jujube | |||||
|---|---|---|---|---|---|
| Sr. No. | Ligands | E. coli Protein with PDB Id 5L3J | S. aureus Protein with PDB Id 2QIL | ||
| 1. | 2-Cyclopenten-1-one,3,4,4-trimethyl- | −4.8 kcal/mol | −5.3 kcal/mol | ||
| 2. | Bis(2-ethylhexyl) phthalate | −5.9 kcal/mol | −7.1 kcal/mol | ||
| Acacia nilotica | |||||
| Sr. No. | Ligands | E. coli proteins | S. aureus proteins | ||
| 1BXW | 3FV5 | 2QIL | 3SEB | ||
| 1. | Suberic acid monomethyl ester | −5.9 kcal/mol | −5 kcal/mol | −5.1 kcal/mol | −5.1 kcal/mol |
| 2. | 2,2,4-trimethyl-1,3-pentanediol di-iso-butyrate | −6.5 kcal/mol | −5.3 kcal/mol | −5.2 kcal/mol | −5.2 kcal/mol |
Disclaimer/Publisher’s Note: The statements, opinions and data contained in all publications are solely those of the individual author(s) and contributor(s) and not of MDPI and/or the editor(s). MDPI and/or the editor(s) disclaim responsibility for any injury to people or property resulting from any ideas, methods, instructions or products referred to in the content. |
© 2023 by the authors. Licensee MDPI, Basel, Switzerland. This article is an open access article distributed under the terms and conditions of the Creative Commons Attribution (CC BY) license (https://creativecommons.org/licenses/by/4.0/).
Share and Cite
Zou, W.; Hassan, I.; Akram, B.; Sattar, H.; Altaf, A.; Aqib, A.I.; Aslam, H.B.; Almutairi, M.H.; Li, K. Validating Interactions of Pathogenic Proteins of Staphylococcus aureus and E. coli with Phytochemicals of Ziziphus jujube and Acacia nilotica. Microorganisms 2023, 11, 2450. https://doi.org/10.3390/microorganisms11102450
Zou W, Hassan I, Akram B, Sattar H, Altaf A, Aqib AI, Aslam HB, Almutairi MH, Li K. Validating Interactions of Pathogenic Proteins of Staphylococcus aureus and E. coli with Phytochemicals of Ziziphus jujube and Acacia nilotica. Microorganisms. 2023; 11(10):2450. https://doi.org/10.3390/microorganisms11102450
Chicago/Turabian StyleZou, Wen, Iram Hassan, Bushra Akram, Huma Sattar, Awais Altaf, Amjad Islam Aqib, Hassaan Bin Aslam, Mikhlid H. Almutairi, and Kun Li. 2023. "Validating Interactions of Pathogenic Proteins of Staphylococcus aureus and E. coli with Phytochemicals of Ziziphus jujube and Acacia nilotica" Microorganisms 11, no. 10: 2450. https://doi.org/10.3390/microorganisms11102450
APA StyleZou, W., Hassan, I., Akram, B., Sattar, H., Altaf, A., Aqib, A. I., Aslam, H. B., Almutairi, M. H., & Li, K. (2023). Validating Interactions of Pathogenic Proteins of Staphylococcus aureus and E. coli with Phytochemicals of Ziziphus jujube and Acacia nilotica. Microorganisms, 11(10), 2450. https://doi.org/10.3390/microorganisms11102450































